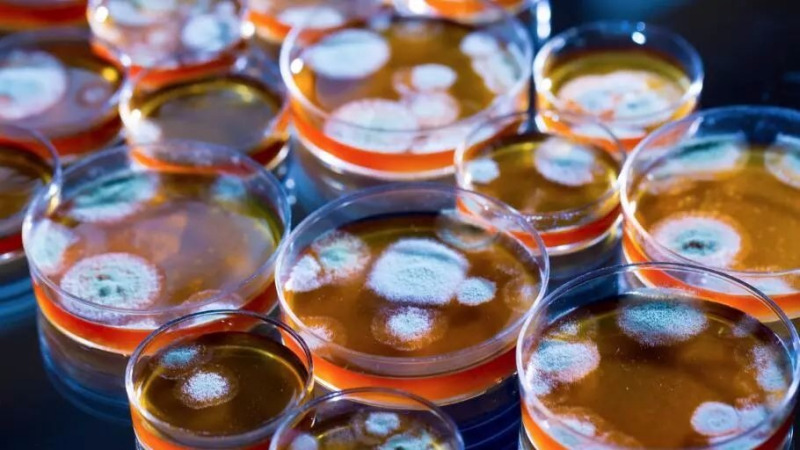
意外!青霉素竟然是这样发现的

搜索"霉素",找到篇相关文章
其他
已完结
//
相信大家对红霉素软膏都比较熟悉,这是一种抗菌消炎的软膏,没有太大的刺激性和不良反应,适用范围也比较广泛。那么红霉素软膏有哪些非常不错的功效呢?下面小编给大家介绍几种红霉素软膏的功效,希望对你有帮助。
其他
已完结
//
红霉素眼膏,是我们平时常用的一种药品,它具有消炎的作用,一般比较多用在治疗眼结膜炎上,有非常好的效果,而我们除了将红霉素眼膏用于眼部疾病外,其实还可以用于其它地方,也有很好的效果,下面我们就一起来看看吧!
其他
已完结
//
青霉素是抗菌素的一种,它是从青霉菌中提取的一种抗生素,它对治疗球菌感染所致的疾病有非常好的疗效,但使用青霉素极易引起药物过敏和不良反应,严重者甚至导致死亡,所以注射青霉素时应注意些什么呢?下面小编为大家简单介绍一下。
其他
已完结
//
现在的小孩子父母都非常关心,一旦有点小毛病,家长都着急的不得了。而当医生选择给小孩打青霉素的时候,家长往往如临大敌,因为他们认为青霉素作为一种抗生素,最好别给孩子用。那6个月大的婴儿可不可打青霉素了呢?